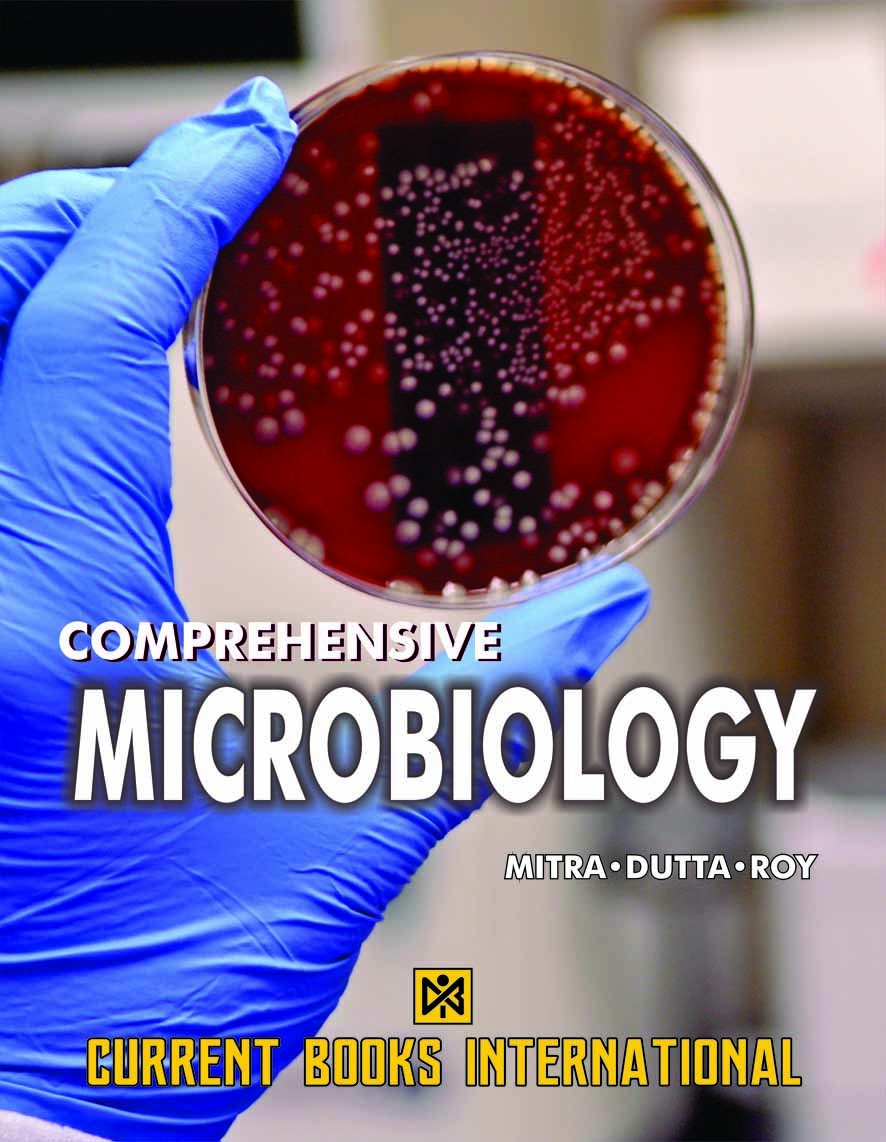
COMPREHENSIVE MICROBIOLOGY

PRACTICAL GUIDE TO MEDICAL MICROBIOLOGY
Price
Rs. 356.00
Rs. 475.00
/Pc
-25%
Share
Top Selling Products
-
Rs. 125.00
Rs. 250.00 -
Rs. 600.00
Rs. 800.00 -
Rs. 525.00
Rs. 700.00 -
Rs. 550.00
-
Rs. 525.00
Rs. 700.00 -
Rs. 488.00
Rs. 650.00
Reviews & Ratings
0
out of 5.0
(0
reviews)
There have been no reviews for this product yet.
Related products
COMPREHENSIVE MICROBIOLOGY
Rs. 425.00
Rs. 850.00
Top Selling Products
-
Rs. 125.00
Rs. 250.00 -
Rs. 600.00
Rs. 800.00 -
Rs. 525.00
Rs. 700.00 -
Rs. 550.00
-
Rs. 525.00
Rs. 700.00 -
Rs. 488.00
Rs. 650.00